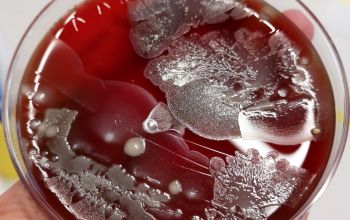

Kerstersia gyiorum
-
General information
Taxonomy
Family: Alcaligenaceae, is a new member of the alcaligenaceae family
Gyiorum (meaning “from the limbs”) was selected as the name of the species because the majority of strains were isolated from human leg wounds.
Clinical significance
Kerstersia gyiorum is an extremely rare pathogen of human infection.
It can cause chronic infection in patients mostly with underlying conditions. They are isolated from wounds, respiratory tract, urine specimens and most frequently from chronic supperative otitis media.
It can easily be misdiagnosed if proper diagnostic methods are not used.
Increased use of MALDI-TOF MS in the clinical setting may increase reporting of this atypical isolate.
-
Gram stain
Gram negative coccobacillus wich appear in singles, pairs and short chains
-
Culture characteristics
-
BA: they appear as flat, opaque, gray colonies with sprading edges
MacConkey agar: non-lactose fermenting.
The colonies have a slight lavender hue, which is especially evident when the colonies are picked up using a swab.
BBAØ: no growth
-
-
Characteristics
-
References
James Versalovic et al.(2011) Manual of Clinical Microbiology 10th Edition
Karen C. Carrol et al (2019) Manual of Clinical Microbiology, 12th Edition